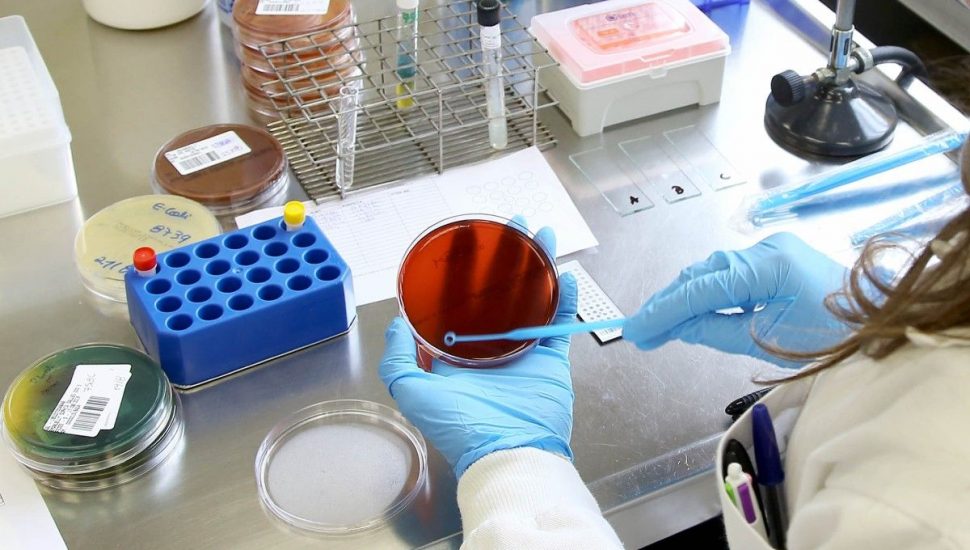

A pandemia de coronavírus no Paraná já atingiu 120.920 pessoas e custou a vida de 3.064 moradores do estado desde seu início, em março. Os números foram atualizados nesta quarta-feira (26) pela Secretaria Estadual da Saúde (Sesa). O boletim epidemiológico desta data aponta 1.680 novos casos e 40 óbitos em decorrência da covid-19.
LEIA MAIS – Coronavírus já é a principal causa de mortes no Paraná em 2020, mas transmissão está em queda
Seguem em investigação 5.627 pacientes com sintomas típicos da doença. Por outro lado, já estão considerados recuperados 80.198 paranaenses – ou seja, 66% do total de infectados.
LEIA AINDA – Curitiba entendeu o recado, diz secretária de saúde sobre combate à covid-19
Das 1.101 UTIs SUS adulto disponíveis exclusivamente para tratamento de pacientes com covid-19, estão ocupados 802 leitos, uma taxa de ocupação de 73%. Estão incluídos nessa conta casos suspeitos e confirmados. Já com relação apenas aos que têm o diagnóstico positivo para o novo vírus, são 1.129 pacientes internados em hospitais públicos e privados, sendo 627 em enfermaria e 502 em UTIs.